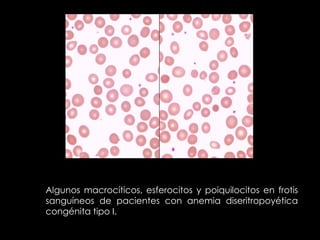
Algunos macrocíticos, esferocitos y poiquilocitos en frotis
sanguíneos de pacientes con anemia diseritropoyética
congénita tipo I.

La anemia diseritropoyética congénita tipo I es un trastorno hereditario causado por una mutación en el cromosoma 15 que causa una anemia crónica moderada a severa, esplenomegalia, y malformaciones congénitas. Este caso describe una paciente diagnosticada con anemia diseritropoyética congénita tipo I a los 11 meses de edad que ha requerido transfusiones regulares y esplenectomía.